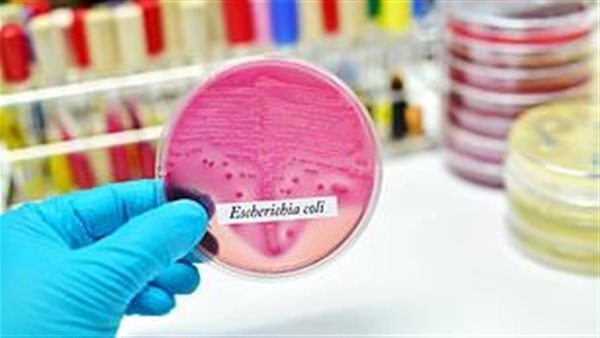
لقاح المسالك البولية

تصيب أكثر من مليون بريطاني سنويا.. اكتشاف لقاح ضد بكتيريا التهاب المسالك البولية
اكتشف باحثون في جامعة دورست، لقاح للحماية من التهابات المسالك البولية، التي تصيب أكثر من مليون بريطاني كل عام، ويساعد هذا اللقاح على تقليل أعداد الأشخاص المصابين.
وقالت لنيكي لاكمان دكتورة الأبحاث الرئيسية في مستشفيات جامعة دورست، إنه سيتم تقديم اللقاح في عدد من المستشفيات كجزء من تجربة تاريخية، وتشمل حقنة واحدة، ويمكن أن توقف الحالات التي تسببها بكتيريا E.Coli الشائعة.
لقاح المسالك البولية
وأضافت لنيكي لاكمان لقد قمنا بالفعل بتوظيف ستة مشاركين، وحالما نحصل على التوقيع النهائي، يمكنهم الحصول على اللقاح يوم الأربعاء المقبل.
بكتيريا E.Coli الشائعة
وتعد بكتيريا تتكون فى أمعاء الناس والحيوانات، وعادة ما تكون غير ضارة، لكنها إذا دخلت في أجزاء معينة فى الجسم تكون خطرة مثل المسالك البولية، ويؤدى ذلك إلى حدوث التهابات متعبة وشديدة وخطيرة في بعض الأحيان.
وصرح الدكتور كات أندرسون، المتخصص في صحة المرأة والالتهابات الميكروبية: يمكن أن تسبب التهابات المسالك البولية عددًا من البكتيريا، لكن الإشريكية القولونية هي السبب في حوالي 90 %.
ويأمل الباحثون الآن في شركة الأدوية جونسون اند جونسون الصيدلانية أن لقاح الإشريكية القولونية يمكن أن يخفف من معاناة الآلاف، وستتيح التجربة للبريطانيين الذين تزيد أعمارهم عن 60 عامًا والذين يعانون على الأقل من عدوى المسالك البولية سنويًا فرصة الحصول على اللقاح.
ويصاب أكثر من مليون بريطاني بالتهاب المسالك البولية، 80 ٪منهم من النساء ويعانون من إحساس شديد بالحرقان عند التبول، ويكون كبار السن أكثر عرضة للخطر، حيث تعمل المثانة بشكل أقل مع تقدم العمر، وقد لا تفرغ بالكامل لذا تبقى البكتيريا في المسالك البولية.
وتعتبر النساء بعد انقطاع الطمث أكثر عرضة للعدوى أيضًا، حيث يساعد هرمون الاستروجين الجنسي الأنثوي في الحفاظ على أنسجة المسالك البولية السفلية والفرج، مع انخفاض المستويات ويمكن أن تصبح الأنسجة أكثر عرضة للخطر.
و تعد المضادات الحيوية حاليًا أحد العلاجات الوحيدة ضد عدوى المسالك البولية، ولكن هذه الأدوية غير فعالة بشكل متزايد بسبب مشكلة البكتيريا التي تنمو مقاومة لها.
وقالت أليسون الأم لطفلين إنها كانت تعاني من عدوى بكتيريا الأشريكية القولونية بعد ولادة ابنها الثاني، وبدأ بألم أسفل البطن، واليرقان، وكأنني أحاول تمرير زجاج عند التبول، وأنها حصلت على مضادات الحيوية على مر السنين، ولا يمكنني التخلص من المضادات الحيوية لمدة تزيد عن 36 ساعة.
وأضافت أليسون أن المضادات الحيوية تجعلني أشعر بالتعب وألهث، مشيرة إلى أنها ستحصل على لقاح الإشريكية القولونية على الفور إذا عُرض عليها، لأن لقاح عدوى المسالك البولية سيغير حياتها، قائلة: “ كل ما أريده هو أن أعيش حياة طبيعية مرة أخرى ”.



















